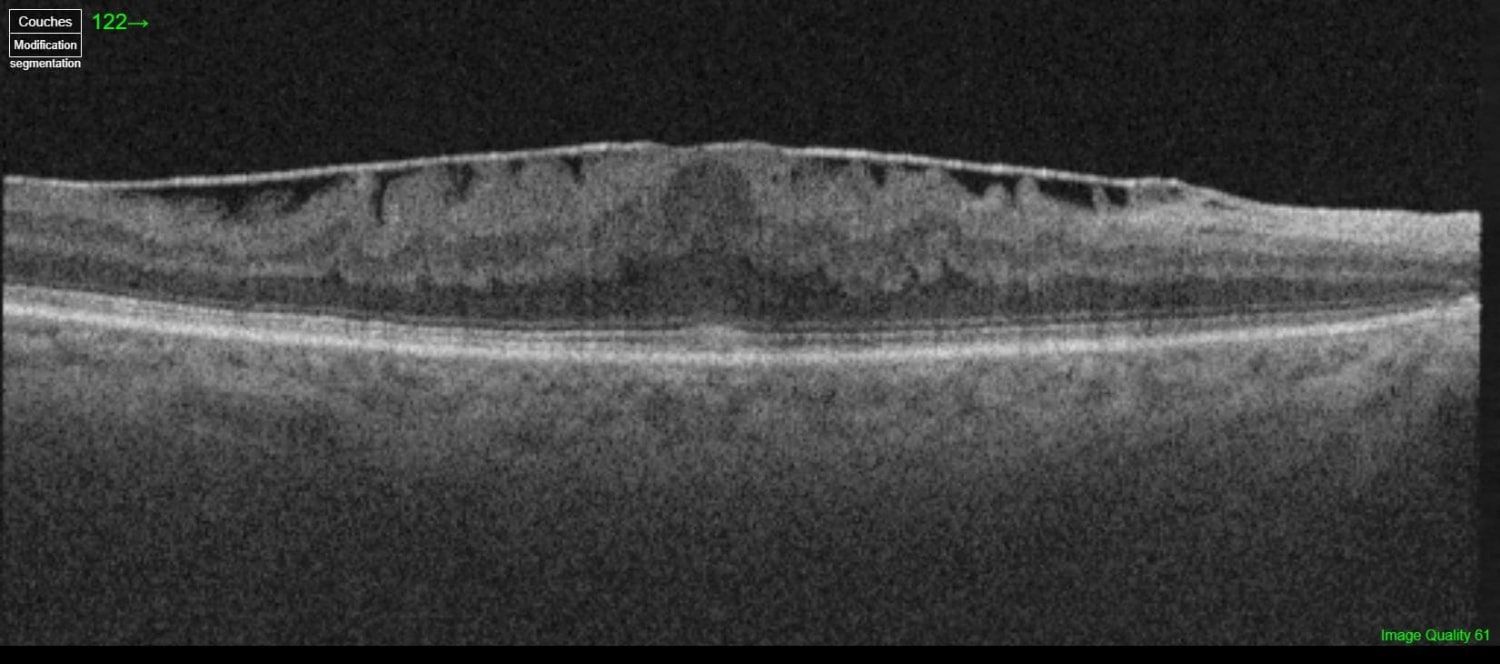

LA MEMBRANE EPIMACULAIRE
Qu'est ce qu'un membrane epimaculaire
La membrane épirétinienne (MER) peut également s’appeler membrane épimaculaire (MEM). Il s’agit d’une couche de cellules qui se forme à la surface de la rétine au niveau de la macula on l’on retrouve le centre de la vision.
On peut schématiser une membrane épirétinienne comme une fine couche de cellophane qui serait déposée sur la rétine, avec le temps celle-ci peut s’épaissir, se contracter et ainsi déformer la macula.
Quels sont les risques ?
Au stade précoce le patient ne ressent aucun symptômes
A long terme et lorsqu’elle est à un stade suffisamment avancé, la membrane epimaculaire est responsable d’une baisse d’acuité visuelle de loin et de près. Elle peut aussi engendrer un scotome central
et des metamorphopsies (déformations des lignes droites).
Comment le détecter ?
Le diagnostic d’une membrane épirétinienne se fait grâce à l’examen de la macula au fond d’œil mais surtout grâce à l’OCT. Il est absolument essentiel. Il permet d‘évaluer l’importance de la membrane au fond d’œil et également l’importance de la déformation de la macula.
Dans la majorité des cas, la membrane épirétinienne est idiopathique (sans cause retrouvée). Elle peut également être secondaire à des maladies comme les décollements de rétine, les OVCR, les rétinopathies diabétiques.
Le traitement de la membrane epimaculaire
Le traitement de la membrane epimaculaire est exclusivement chirurgical. L'indication opératoire est posée en fonction de plusieurs paramètres notamment l'importance de la baisse d'acuité visuelle et la gêne ressentie par le patient.